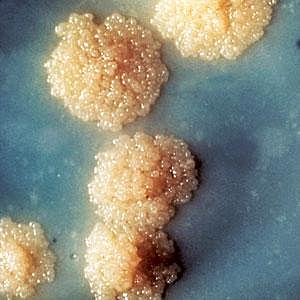
Robert Koch

-
Refuta por primera vez la generación espontánea en gusanos.
-
Observa por primera vez bacterias o "animálculos".
-
Demostró que no existe la generación espontánea de la vida, abriendo camino a las teorías de Pasteur.
-
Desarrolla la primera vacuna contra la viruela humana.
-
Descubre la pasteurización, que es un proceso usado para destruir microorganismos dañinos en productos comestibles.
-
Refuta de manera convincente la teoría de la generación espontánea.
-
Demostró que los métodos antisépticos eran fundamentales para evitar la infección de las heridas.
-
Demuestra que el carbunco o ántrax es causado por Bacillus anthracis.
-
Descubre el Mycobacterium tuberculosis.
-
Publica los postulados de Koch.
-
Descubre el papel de la fagocitosis que le ayudó con su teoría de la inmunidad celular.
-
Puso a punto una vacuna contra la rabia.
-
Demuestra que el mosaico del tabaco es producido por un virus.
-
Publica su teoría de la inmunidad de cadena lateral.
-
Descubre el primer agente quimioterapéutico contra la sífilis.
-
Descubre la lisozima.
-
Aísla la penicilina de un cultivo de Penicillium notatum.
A list shows items. A timeline shows sequence.
Use Timetoast to make dates, milestones, and turning points easier to understand in a clear visual format. Timetoast is a timeline maker for work, school, research, and stories.